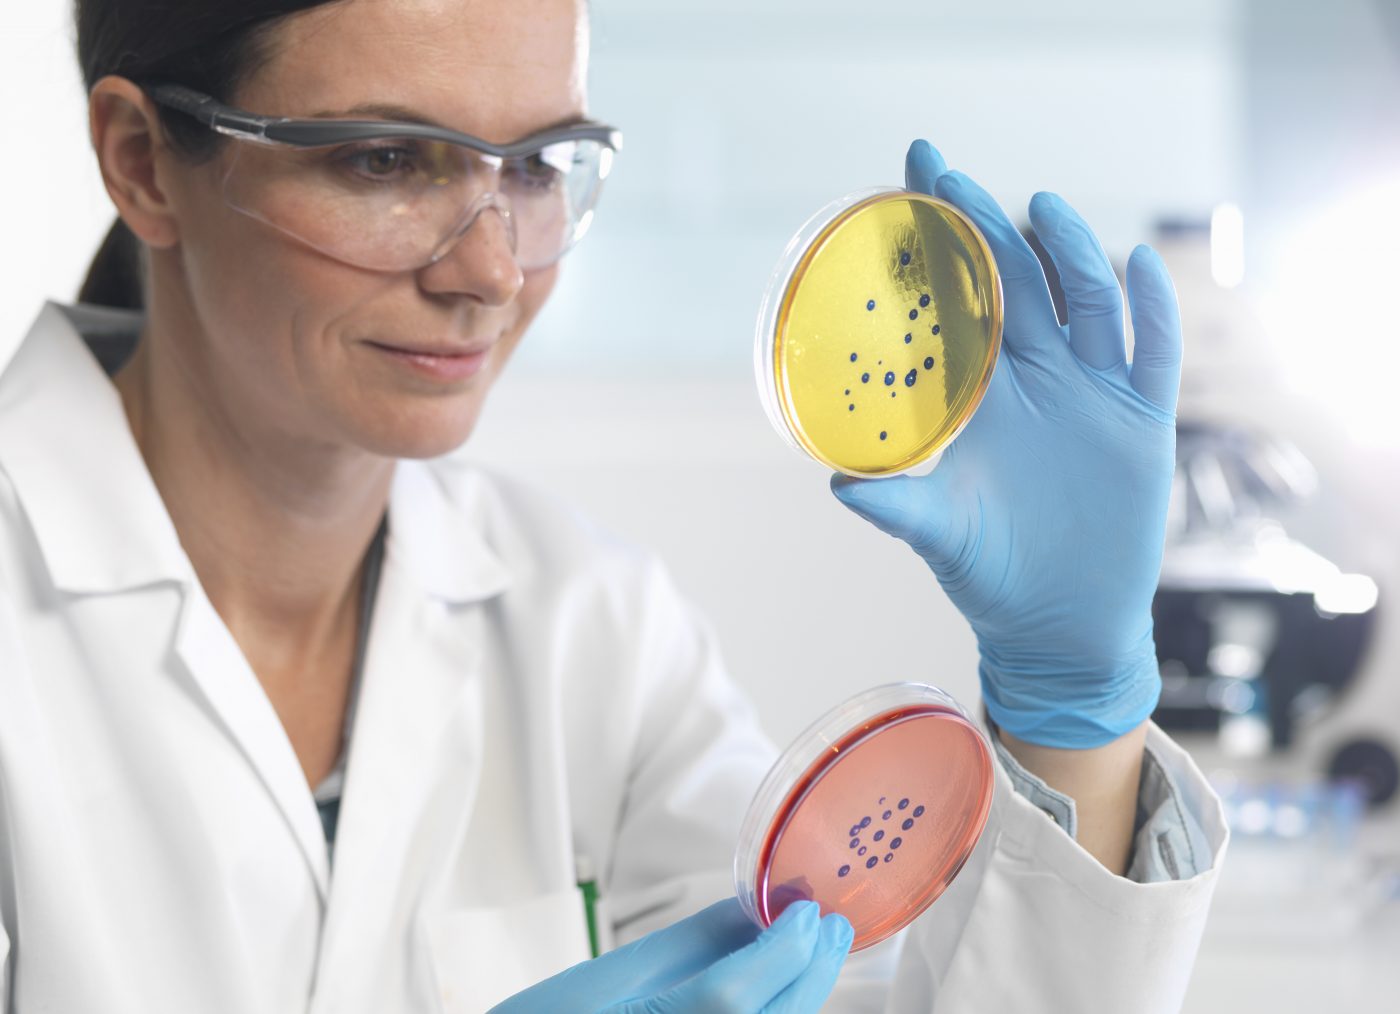
Grado en Microbiología Grado en Microbiología

Tabla de Contenidos
¿Qué es el Grado en Microbiología?
El Grado en Microbiología se enfoca en el estudio de los microorganismos, como bacterias, virus, hongos y protozoos, y su impacto en los seres vivos y en el medio ambiente. Esta carrera permite a los estudiantes comprender los procesos biológicos y genéticos de los microorganismos y su relación con la salud, la industria y el entorno. El grado abarca temas como la biotecnología, la inmunología y la microbiología ambiental, y dota a los estudiantes de las habilidades necesarias para investigar y manejar los microorganismos en diferentes ámbitos.
Estudiar Microbiología ofrece una visión integral sobre los microorganismos y sus aplicaciones, así como su rol en enfermedades y procesos biológicos. Si deseas saber si esta carrera es ideal para ti, realiza nuestro Test inteligente y descubre si tienes el perfil adecuado para el Grado en Microbiología.
Perfil del estudiante del Grado en Microbiología
El estudiante ideal para este grado suele contar con las siguientes características:
- Interés en la biología y en los microorganismos: Los futuros microbiólogos suelen tener una gran curiosidad por el mundo microscópico y su funcionamiento.
- Habilidades en investigación y análisis: La capacidad de analizar datos y realizar investigaciones es fundamental para estudiar y entender los microorganismos.
- Inclinación por la química y la genética: El grado requiere conocimientos en estos campos para comprender los procesos bioquímicos y genéticos en los microorganismos.
- Capacidad de trabajo en laboratorio: Es importante sentirse cómodo en entornos de laboratorio y manejar instrumental técnico con precisión y responsabilidad.
- Interés por la salud y la industria: Muchos microbiólogos trabajan en el ámbito sanitario, farmacéutico o alimentario, donde los microorganismos juegan un rol esencial.
Salidas laborales del Grado en Microbiología
Los graduados en Microbiología tienen un abanico de opciones laborales en sectores como la salud, la investigación y la industria. Algunas de las salidas profesionales más comunes son:
- Microbiólogo clínico: Trabajar en laboratorios de diagnóstico en hospitales y centros de salud para identificar agentes infecciosos y contribuir a la prevención y tratamiento de enfermedades.
- Investigador en microbiología y biotecnología: Desarrollar investigaciones en universidades o centros de investigación sobre la genética y el comportamiento de microorganismos.
- Microbiólogo industrial: Trabajar en el control de calidad y la producción en industrias alimentarias, farmacéuticas y de biotecnología.
- Técnico en biocontrol: Aplicar microorganismos en la agricultura y otras industrias para el control de plagas y enfermedades.
- Inmunólogo o especialista en enfermedades infecciosas: Colaborar en el desarrollo de vacunas y tratamientos para enfermedades infecciosas.
- Consultor ambiental en microbiología: Asesorar sobre la gestión de microorganismos en entornos naturales y urbanos, incluyendo la remediación de áreas contaminadas.
- Profesor e investigador académico: Enseñar y realizar investigaciones en microbiología en instituciones educativas y de investigación.
Plan de estudios
Primer y Segundo Año: Fundamentos de Microbiología y Ciencias de la Vida
- Introducción a la microbiología y a los microorganismos
- Bioquímica y biología celular
- Genética general y genética de microorganismos
- Química orgánica aplicada a la microbiología
- Microbiología general y técnicas de laboratorio
- Inmunología básica
- Ecología microbiana
- Estadística aplicada a las ciencias biológicas
- Fisiología de microorganismos
Tercer Año: Especialización en Microbiología Aplicada
- Microbiología médica e infecciosa
- Biotecnología y microbiología industrial
- Virología y enfermedades virales
- Microbiología ambiental
- Bacteriología y enfermedades bacterianas
- Micología y parasitología
- Técnicas avanzadas en laboratorio microbiológico
- Epidemiología y salud pública
Cuarto Año: Aplicación Profesional y Proyecto Final
- Microbiología de los alimentos y control de calidad
- Microorganismos en la biodegradación y biorremediación
- Tecnología de los productos antimicrobianos
- Prácticas en laboratorios clínicos o de investigación
- Legislación y ética en microbiología
- Trabajo de Fin de Grado (TFG)
Nuestra Conclusión
El Grado en Microbiología es una carrera apasionante para aquellos interesados en entender el papel de los microorganismos en la salud, la industria y el medio ambiente. Este grado proporciona una sólida base científica y ofrece un amplio abanico de oportunidades laborales en áreas como la salud pública, la biotecnología y la investigación. Los conocimientos adquiridos capacitan a los graduados para contribuir a la solución de problemas globales, como el control de enfermedades infecciosas, la mejora de procesos industriales y la protección del medio ambiente.